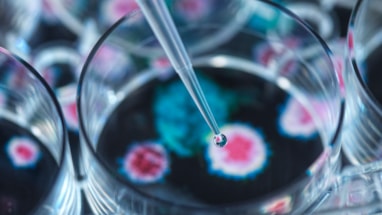
Petriskål med voksende bakterie og pipette som drypper ned

Analysene er utarbeidet fra 2015 og frem til i dag, og dekker både naturhendelser, store ulykker, tilsiktede hendelser og forsyningssvikt. I oversikten under finner du korte sammendrag med lenker til rapportene.
Tilsiktede hendelser
Naturhendelser
Helserelaterte hendelser
Forsyningssvikt
Branner
Analyser av krisescenarioer (2019)
Samleutgaven av Analyser av krisescenarioer (2019), som flere av analysene over er hentet fra, er fortsatt tilgjengelig i DSBs rapportarkiv. Rapporten kan brukes til inspirasjon i arbeid med risikoanalyser, men inneholder analyser med utdatert og mangelfull informasjon og bør derfor brukes med varsomhet som kilde for nye analyser.
I dette metodedokumentet beskriver vi prosessen og metoden bak arbeidet med AKS 2019. Slik vil vi legge til rette for transparens og etterprøvbarhet av vurderinger og resultater, samt beskrive en metode for risikoanalyser som med nødvendige tilpasninger også kan brukes i andre sammenhenger.